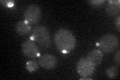
YJL085W
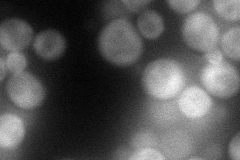
YJL085W
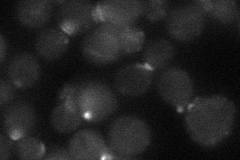
YJL085W
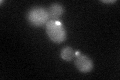
YJL085W
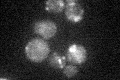
YJL085W

View description
Subunit of the exocyst complex (Sec3p, Sec5p, Sec6p, Sec8p, Sec10p, Sec15p, Exo70p, and Exo84p), which directs secretory vesicles to active sites of exocytosis; acts with Sec3p in membrane targeting of the exocyst via PI(4,5)P2 binding
Localization:
Intensity:
Fold change:
Significance:
-
C’ GFP library in SD
bud neckN/A -
N' NOP1pr-GFP in SD

cytosol,bud neck81.9941 -
N' TEF2pr-mCherry in SD
bud90.396 -
N' NATIVEpr-GFP in SD
bud23.4814 -
N' TEF2pr-VC and Cyto-VN in SD

cytosol45.2979 -
C’ GFP library in SD+DTT
bud neck25.961.15No -
C’ GFP library in SD+H2O2

cytosol23.81.05No -
C’ GFP library in Starvation Media
bud neck29.161.29No -
C’ GFP library on the background of Pup2-DaMP

bud neck -
C’ GFP library on the background of CCT mutant

bud neck20.26290.89894No
